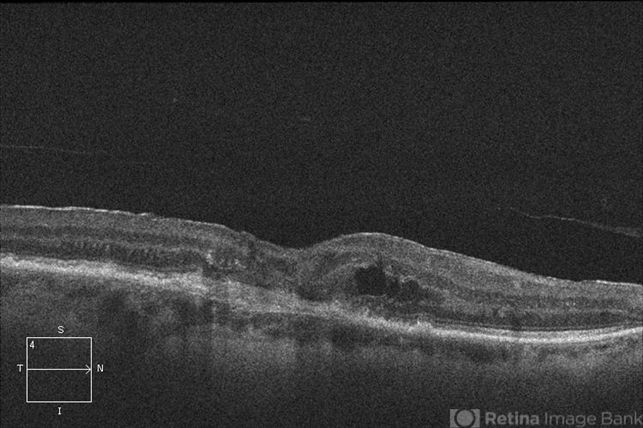

-
 By Alex P. Hunyor, MD
By Alex P. Hunyor, MD
Retina Associates - Uploaded on Dec 23, 2012.
- Last modified by Chayal Patel on Dec 26, 2012.
- Reviewed by Chayal Patel
- Rating
- Appears in
- Spontaneous RPE rip in NV AMD
- Condition/keywords
- pigment epithelial detachment (PED), retinal pigment epithelium (RPE) tear
- Imaging device
- Optical coherence tomography system
- Description
- 80-year-old female with subfoveal occult CNV and large extrafoveal PED which underwent spontaneous RPE rip. OCT shows subfoveal CNV and intraretinal cystic edema

Initializing download.
Initializing download.










